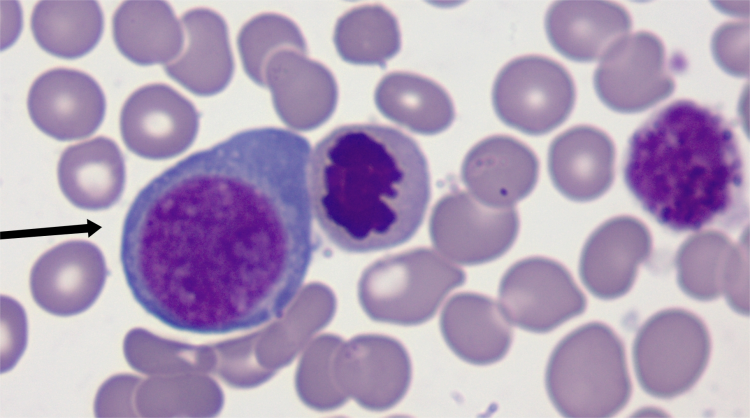

【第一百四十三期】基层检验网形态学培训
【第一百四十期三】基层检验网形态学培训
每周一次,每次几张,只要您坚持来,抽出几分钟的时间,相信您的识图能力会不知不觉的提升哦
1、请写出图中箭头所指细胞名称:(骨髓,瑞氏染色,10x100 倍) :

答案:原始粒细胞
解析:外形呈圆形或类圆形;胞核较大,圆形或椭圆形,居中或略偏位,核染色质呈细颗粒状,平坦如薄沙样;核仁2-5个,较小,一般较清晰,呈淡蓝色;胞质量较少,呈蓝色或灰蓝色。
2、请写出图中箭头所指细胞名称:(骨髓,瑞氏染色,10x100 倍):

答案:小巨核细胞
解析:其大小类似淋巴细胞,因此有时被称为淋巴样巨核细胞,属于成熟巨核细胞;胞体多为圆形或椭圆形,胞质边缘不整齐,呈毛刺状或有伪足样突起;细胞胞核呈圆形或椭圆形,多为1个,有时可见2个核;核染色质致密浓染,无核仁,胞质呈云雾状或含有较多细小紫红色颗粒,有时可见多少不等的血小板脱落。
3、请写出图中箭头所指细胞名称:(骨髓,瑞氏染色,10x100 倍)
答案:原始红细胞
解析:外形呈圆形或椭圆形,并常见瘤状突起。细胞核圆形且多居中,核染色质呈细颗粒状,核仁多为1-3个;细胞质深蓝色、呈不透明油墨蓝,在核周围常有半月形淡染区形成,因核糖体丰富使胞质染色后呈现出蓝色“颗粒”状。
4、请写出图中箭头所指细胞名称:(骨髓,瑞氏染色,10x100 倍):

答案:中幼红细胞巨幼变
解析: 胞体较正常中幼红细胞明显增大,胞核圆形,核染色质疏松似蚕食感,无核仁,核浆发育不平衡,呈“幼核老浆”现象,常见于巨幼细胞性贫血。
5、请写出图中箭头所指细胞名称:(骨髓,瑞氏染色,10x100 倍):

答案:嗜酸性中幼粒细胞
解析: 比中性中幼粒细胞略大。细胞核形与中性中幼粒细胞类似。胞质内充满部分紫褐色和橘红色粗大、排列紧密并有立体感及折光性的嗜酸性颗粒。
感谢:重医大附一院检验科和其它医院提供的内容。


